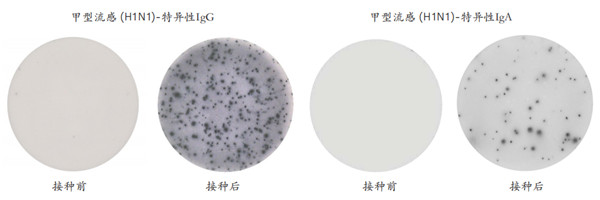
人 IgG 和 IgA ELISpot .jpg

公司新闻/正文
845 人阅读发布时间:2021-09-07 11:40
【前情提示】
说起ELISA人人都知道,它的“表兄弟”ELISpot你就不一定清楚了。
什么是ELISpot (统计能够分泌某种蛋白的细胞的数量)?
酶联免疫斑点法技术,ELISpot,是一种用于在单细胞水平上对分泌细胞因子或免疫球蛋白的细胞进行定量的灵敏分析方法。细胞分泌的细胞因子、免疫球蛋白或其他靶蛋白在分泌后立即被特异性抗体捕获,并在整个刺激过程中被持续捕获。ELISpot可以在25万个细胞中检测出一个有响应的细胞,是最灵敏的细胞分析方法之一。该检测方法稳健且易于操作,因此既适用于大规模试验,也适用于实用研究。ELISpot已被广泛应用于研究感染性疾病、癌症、过敏和自身免疫性疾病的特异性免疫反应,以及特别热门的新冠病毒疫苗开发领域。
ELISpot实验步骤与原理示意 (示意图如下)?
大致原理上分为如下7个步骤,详情已具体产品说明书为准
Step.1 包被:将单克隆捕获抗体添加到乙醇处理的PVDF膜板上
Step.2 细胞孵育:在有刺激的情况下加入细胞,孵育,细胞分泌细胞因子
Step.3 捕获分泌物:激活后的细胞,分泌的细胞因子被周围的抗体结合捕获
Step.4 检测抗体:去除细胞,清洗平板,加入生物素化的检测抗体
Step.5 链霉亲和素-酶偶联物:加入链霉亲和素偶联物,保证后续在膜上形成斑点
Step.6 加反应底物:当酶催化时,显色底物形成不溶性沉淀
Step.7 结果分析:在自动点阅读器中对结果进行分析。每个斑点对应一个
分析物分泌细胞

ELISpot通常用于哪些领域呢?
ELISpot常见的领域包括:T细胞/B细胞功能研究、自身免疫检测、器官移植、疫苗和药品的研发与检测、肿瘤研究、传染病的研究和检测、病毒研究等。下面简单讲述一下T细胞,B细胞的ELISpot分析应用:
T细胞的ELISpot
ELISpot是研究特异性免疫反应的敏感方法,能够区分活化的T细胞亚群。例如,Th1细胞产生干扰素-γ、IL-2和TNF-α,而Th2细胞产生其他细胞因子,如IL-4、IL-5和IL-13。例如,这被广泛应用于传染病、癌症、过敏和自身免疫性疾病的研究。
在疫苗研究中,ELISpot是一种标准工具,用于通过测量激发强大T细胞反应的能力(通常是干扰素-γ的分泌)来确定疫苗的有效性。今天,基于ELISpot的诊断分析已经可用,包括一种通过测量T细胞对结核分枝杆菌特定抗原的反应分泌干扰素-γ来检测结核病感染患者的测试。

人干扰素γ( IFN-γ) ELISpot:分别在无刺激,抗CD3,植物血凝素(PHA)和纯化蛋白衍生物
(PPD)孵育过夜条件下,检测分析外周血单核细胞(PBMC)分泌IFN-γ情况。
B细胞的ELISpot
B细胞ELISpot分析是分析抗体免疫反应的有力工具,并且是仅有的少数能直接聚焦于 抗体分泌细胞(ASC)的分析方法之一。 这种极为灵敏的方法使研究人员能够识别样 品中的ASC,并测量其总数以及那些对特定抗原分泌抗体的数量。
例如,B细胞ELISpot可以揭示血液中长期记忆B细胞的数量,这是无法用其他方法评 估的。B细胞ELISpot的主要应用包括检测B细胞对感染的反应和疫苗引发的反应。
人 IgG 和 IgA ELISpot :用Pandemrix接种前后,收集PBMC,并通过ELISpot分析甲型流感病毒
(H1N1)特异性IgG(左) 和IgA(右)的分泌情况
如何挑选合适的ELISpot产品呢?
作为专业的生命科学与医药产品方案供应商,艾美捷科技为您梳理:
【1】ELISpot试剂盒类型:
针对不同的研究需要,我们使用不同格式的ELISpot试剂盒,从ELISpotBASIC到完整的ELISpotPRO试剂盒。 未涂层的ELISpot板和底物也可以单独购买。
| ELISpot BASIC 基础自开发款 |
ELISpotPLUS 预包被 |
ELISpotPRO 一步法 |
|
| 客户偏好 | 想要设置和优化实验,开发kit的客户 | 大部分客户的选择 | 最短实验时间 |
| ELISpot 板子 | —— | 预包被 | 预包被,可拆卸孔板 |
| 捕获抗体(单抗) | √ | 存在于预包被的板子中 | 存在于预包被的板子中 |
| 检测抗体(单抗)- ALP/HRP | —— | —— | √ |
| 生物素化检测抗体(单抗) | √ | √ | —— |
| 链霉亲和素- ALP/HRP | √ | √ | —— |
| 底物 | —— | √ | √ |
| 阳性对照刺激物 | —— | Anti-CD3 单抗 | Anti-CD3 单抗 |
| 规格 | 试剂足够用于组装4个板子 | 2 或 10 个板子 | 2 或 10 个板子 |
【2】分析物(指标)与种属的对应表格(如下指标均有对应产品):
| 人 | 非人类灵长类 | 小鼠 | 牛 |
| Amyloid-β | apoA1 | apoA1 | IFN-γ |
| apoA1 | apoB | apoE | IgG |
| apoB | apoE | CD40 | IL-2 |
| apoD | apoH | IFN-α pan | IL-4 |
| apoE | CD3 | IFN-γ | IL-8 (CXCL8) |
| apoH | CD28 | Ig | IL-17A |
| apoJ (Clusterin) | GM-CSF | IgA | |
| apoM | IFN-α pan | IgE | 马 |
| CD3 | IFN-γ | IgEa | IFN-γ |
| CD4 | IgA | IgG | IL-17A |
| CD8 | IgG | IgG1 | |
| CD28 | IgG1 | IgG2a | 绵羊 |
| CD40 | IgG2 | IgG2b | IFN-γ |
| CD43 | IgM | IgG2c | IL-2 |
| EBI3 | IL-2 | IgG3 | IL-4 |
| Galectin-3 | IL-4 | IgM | IL-17A |
| GM-CSF | IL-5 | IL-1α | |
| Granzyme A | IL-6 | IL-2 | 山羊 |
| Granzyme B | IL-8 (CXCL8) | IL-4 | IFN-γ |
| IFN-α2 | IL-12 (p70) | IL-5 | IL-4 |
| IFN-α pan | IL-12/-23 (p40) | IL-6 | IL-17A |
| IFN-γ | IL-13 | IL-10 | |
| Ig | IL-17A | IL-12 (p70) | 猪 |
| IgA | IL-21 | IL-12/-23 (p40) | IFN-γ |
| IgA1 | IL-23 | IL-17A | IgG |
| IgE | Perforin | IL-22 | IL-2 |
| IgG | TGF-β1 (Latent TGF-β1) | SARS-CoV-2 | IL-17A |
| IgG1 | TNF-α | TNF-α | Perforin |
| IgG2 | TNF-α | ||
| IgG3 | 大鼠 | ||
| IgG4 | IFN-γ | 狗 | |
| IgM | IgG | IFN-γ | |
| IL-1α | IgG2a | IL-8 (CXCL8) | |
| IL-1β | IL-22 | IL-17A | |
| IL-2 | |||
| IL-3 | 棉鼠 | 猫 | |
| IL-4 | IFN-γ | IFN-γ | |
| IL-5 | |||
| IL-6 | 仓鼠 | 雪貂 | |
| IL-8 (CXCL8) | IFN-γ | IFN-γ | |
| IL-10 | IL-2 | ||
| IL-12 (p70) | 豚鼠 | ||
| IL-12/-23 (p40) | IFN-γ | 骆驼 | |
| IL-13 | IFN-γ | ||
| IL-17A | 兔 | ||
| IL-21 | IFN-γ | 羊驼 | |
| IL-22 | IgG | IFN-γ | |
| IL-23 | |||
| IL-27 | 土拨鼠 | 犀牛 | |
| IL-29 (IFN-λ1) | IFN-γ | IFN-γ | |
| IL-31 | |||
| Perforin | 鸡 | ||
| SARS-CoV-2 | IFN-γ | ||
| TGF-β1 (Latent TGF-β1) | |||
| Thioredoxin-1 | 鲑鱼 | ||
| TNF-α | IFN-γ |
* 以上产品仅适用于科学研究使用.
................................................................................................
看到这儿,您心动了吗?马上联系小艾吧!
或者扫描下方二维码,即可联系您的专属客服哦~

作为一家具有高端的技术实力、先进的经营管理水平和完善的市场销售体系的生物高科技企业,总部位于武汉光谷高新技术开发区,服务面向全国。艾美捷科技是集进口试剂、实验室耗材销售、技术服务与合约开发为一体的专业化高科技公司,为用户提供专业的前沿资讯、完备的产品、整合的解决方案,及优质的物流服务。